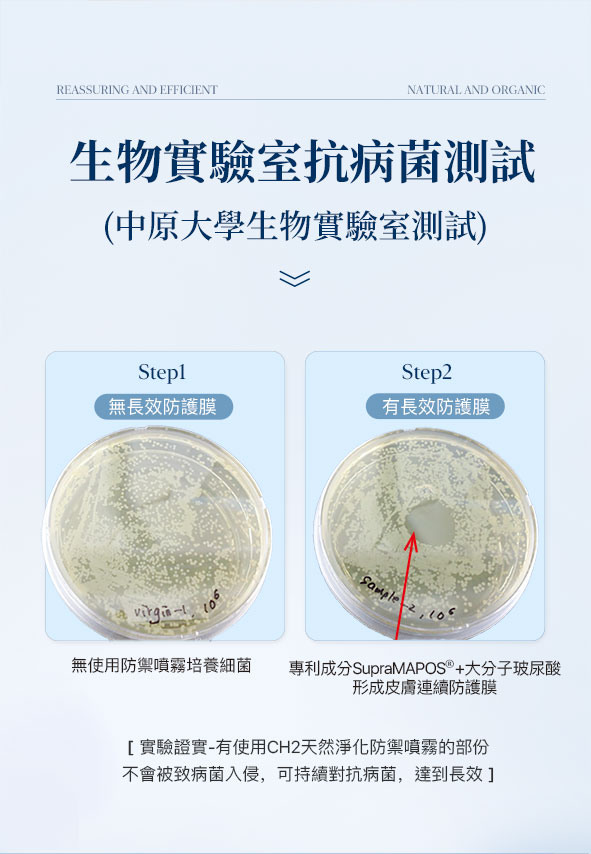

【商品介紹】
CH2 天然淨化防禦噴霧是一款以「安全防護」與「溫和配方」為核心設計理念的日常防護噴霧,採用99.5%以上天然成分,融合專利抗菌技術 SupraMAPOS®,在1分鐘內即能達成99.9%抗菌率,適用於日常手部、身體肌膚或物品表面噴灑使用,溫和有效。
配方不含酒精、四級銨鹽、氯系物質及香精,無刺鼻氣味,不會造成肌膚乾裂或刺激,特別適合嬰幼兒、孕婦及敏感性肌膚族群使用。
產品兼具抗菌、保濕與修護三大功能,能有效維持肌膚水分與健康防護力。
pH值為5.2的弱酸性配方貼近人體肌膚,長效抗菌效果可達24小時,經實驗測試證實安全可靠。輕巧瓶身設計方便隨身攜帶,適合放入包包、口袋或兒童書包中,一瓶約可使用超過250次,是通勤、旅遊、校園生活及公共場所的理想防護用品。
CH2 天然淨化防禦噴霧不僅守護健康,更守護您的生活品質。
.
【產品使用時機】
✔手部或身體肌膚、環境物品、個人用品、寵物
✔抗衰修復,膚況調理,保濕定妝
✔嬰幼兒敏弱肌適用
✔洗澡後噴臉,有機玻尿酸保濕外,可抗菌抗痘
✔洗澡後,噴於外陰胯下,預防毛囊炎等皮膚不適
✔私密除毛後幫助舒緩皮膚敏感刺激
✔外出作為手部抗菌防疫噴霧,取代酒精,不乾澀越噴越保濕
.
【注意事項】
✔請避免誤觸眼睛 / 只限外用。
✔若有不適,請停止使用並諮詢醫師
.













【產品規格】
品名:CH2 天然淨化防禦噴霧
容量:50 mL/瓶
成分:純水、SupraMAPOS® 抗菌複合物、植物甘油、玻尿酸、檸檬酸等天然成分
使用方式:噴灑於手部、臉部或物品表面,靜待自然乾燥
保存方式:常溫保存,避免陽光直射,效期三年
適用對象:適合嬰幼兒、孕婦及敏感肌膚
產品特色:抗菌、保濕、修護三效合一;無香精、無酒精、無刺激成分
產地:台灣製造
保固資訊:此產品屬消耗品,開封後請儘早使用完畢以確保效能
.
【保固說明】
【廠商名稱】海之鑰生技股份有限公司
【投保產品責任險字號】22A0008530
.
◆退(換)貨注意事項:
本私密產品不接受退貨,請同意再下單
◆配送注意事項:
本產品係由供應商提供台灣本島(貨運一般區)免費商品運送服務。若指定配送區為離島、花東與偏遠特殊地區,將不在此(免費)服務範圍內!
商品評價
此商品暫無評價